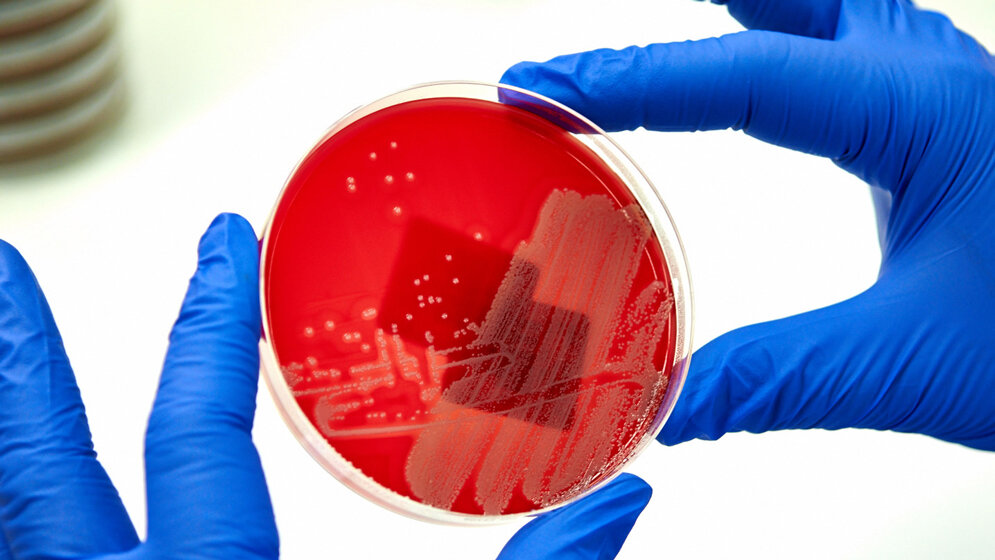
newsimage281208.jpgKeime.jpg Keime

Alltag am Flughafen: Bis zum Start des Jets, der seine Passagiere in ferne Lande bringt, dauert es noch – Zeit genug, um schnell die Toilette aufzusuchen. Was die Reisenden dort erwartet, ist nicht immer ein schöner Anblick. Wesentlich schlimmer allerdings kann das sein, was sie nicht sehen: Wie Wissenschaftler der Westfälischen-Universität Münster (WWU) in Zusammenarbeit mit dem Robert-Koch-Institut in Berlin jetzt nachgewiesen haben, sind die Toiletten auf Flughäfen auch für Keime ein „Umsteigepunkt“.
Auf Abstrichen von inneren Türklinken zahlreicher Toilettenkabinen fanden die Forscher weltweit Keime - darunter auch solche gegen die herkömmliche Antibiotika zur Behandlung bakterieller Infektionen nicht oder nur eingeschränkt wirken. Als „blinde Passagiere“ reisen sie quer durch die Welt, zum Beispiel von Indien nach Frankreich. Seine Erkenntnisse hat das Team jetzt in der Fachzeitschrift „Clinical Microbiology and Infection“ veröffentlicht.
Insgesamt untersuchten die Forscher um Frieder Schaumburg und Karsten Becker, beide vom Institut für Medizinische Mikrobiologie des Universitätsklinikums Münster, 400 Türklinken von 136 Flughäfen in 59 Ländern. Die Abstriche stammen aus der Zeit von Dezember 2012 bis November 2015.
Die Türklinke ist besonders mit Keimen belastet
Die inneren Türgriffe der Toilettenkabinen eignen sich besonders als Untersuchungsobjekt: „Eine Türklinke wird von einer Vielzahl an Menschen genutzt. Zudem ist sie der letzte Kontakt, den die Besucher nach dem Toilettengang haben, bevor sie sich die Hände waschen. Die Türklinke ist dann besonders mit Keimen beispielsweise der Haut und des Darms belastet“, so Schaumburg.
Von den Türklinken-Abstrichen wurden die daran haftenden Keime auf Spezialnährmedien angezüchtet und identifiziert. Die Forscher analysierten die Spezies und das Erbgut jedes gefundenen Erregers. Besonders häufig fanden sie den Staphylococcus aureus, der mit 5,5 Prozent etwa bei jeder zwanzigsten Probe auftrat, gefolgt von Stenotrophomonas maltophilia (2 %) und Acinetobacter baumannii (1,3 %). Einige dieser Erreger wiesen Resistenzen auf.
Die Annahme der Forscher, dass Fluggäste auch sogenannte multiresistente Superkeime von Reisen in ferne Länder in ihr Heimatland mitbringen können, wird durch die Funde bestätigt. „Einer der gefundenen MRSA-Erreger, festgestellt in einer Probe aus Paris, war höchst ungewöhnlich für diese Region. Hauptsächlich kommt er in Indien vor. Er muss also vom Menschen dorthin gebracht worden sein“, erläutert Becker.
Das Brisante daran: Methicillin-resistente S. aureus-Erreger (MRSA), sind alles andere als harmlose Bakterien. Sie stellen eine erhebliche Gefahr für Menschen dar, denn sie können, wenn sie ins Körperinnere gelangen, zu Infektionen an verschiedensten Stellen des Körpers führen. Dabei sind diese Erreger resistent gegen die am besten wirksamen Antibiotika, wie Penicillin und verwandte Substanzen.
Gründliches Händewaschen ist ein Muss
Auch wenn die gefundene Belastung der untersuchten Türklinken insgesamt gering ist: Die Studie aus Berlin und Münster belegt, dass international reisende Fluggäste gefährliche Erreger – bis hin zu „Superkeimen“ – erwerben und verbreiten können.
Der Rat, den die Autoren angesichts dieser Erkenntnis geben, ist nicht neu, aber unvermindert wichtig: „Egal an welchem Ort beziehungsweise Örtchen: Das gründliche Händewaschen nach der Toilettenbenutzung ist ein Muss. Auf öffentlichen Toiletten sollte der Hautkontakt mit Oberflächen so gering wie möglich gehalten werden, und die alternative Nutzung eines alkoholischen Händedesinfektionsmittels anstatt von Seife ist hier – nicht aber im normalen häuslichen Umfeld – sinnvoll“, empfiehlt Karsten Becker.
Quelle: idw/Westfälische Wilhelms-Universität Münster , 08.11.2016
Artikel teilen